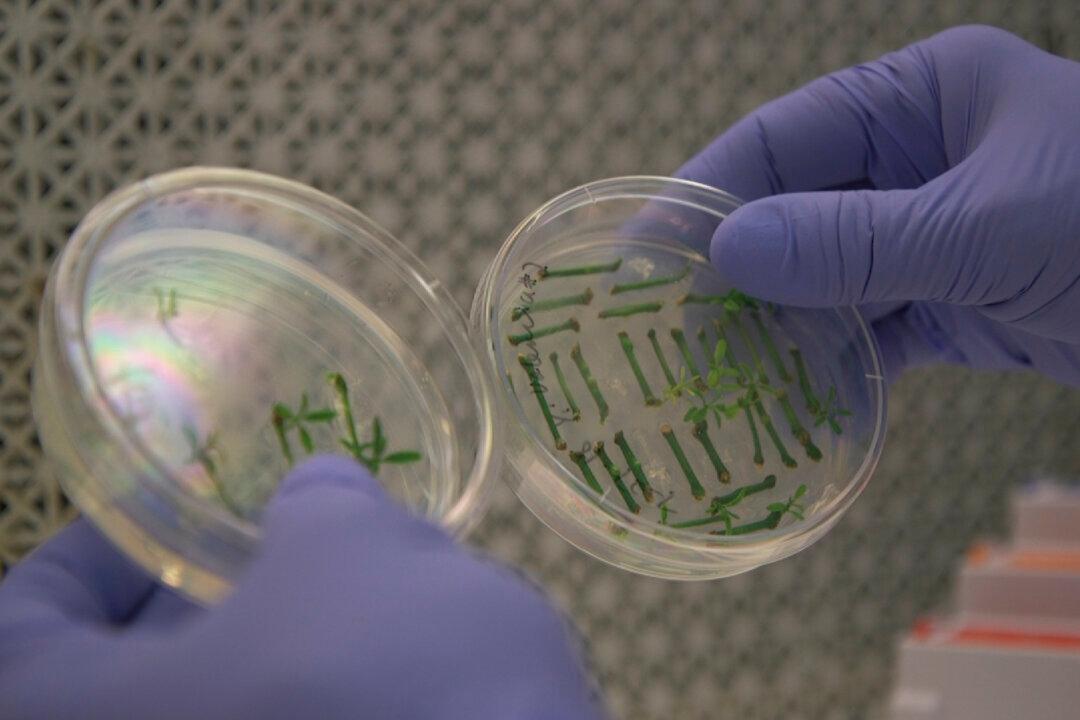

WASHINGTON—The next generation of biotech food is headed for the grocery aisles, and first up may be salad dressings or granola bars made with soybean oil genetically tweaked to be good for your heart.
By early next year, the first foods from plants or animals that had their DNA “edited” are expected to begin selling. It’s a different technology than today’s controversial “genetically modified” foods, more like faster breeding that promises to boost nutrition, spur crop growth, and make farm animals hardier and fruits and vegetables last longer.